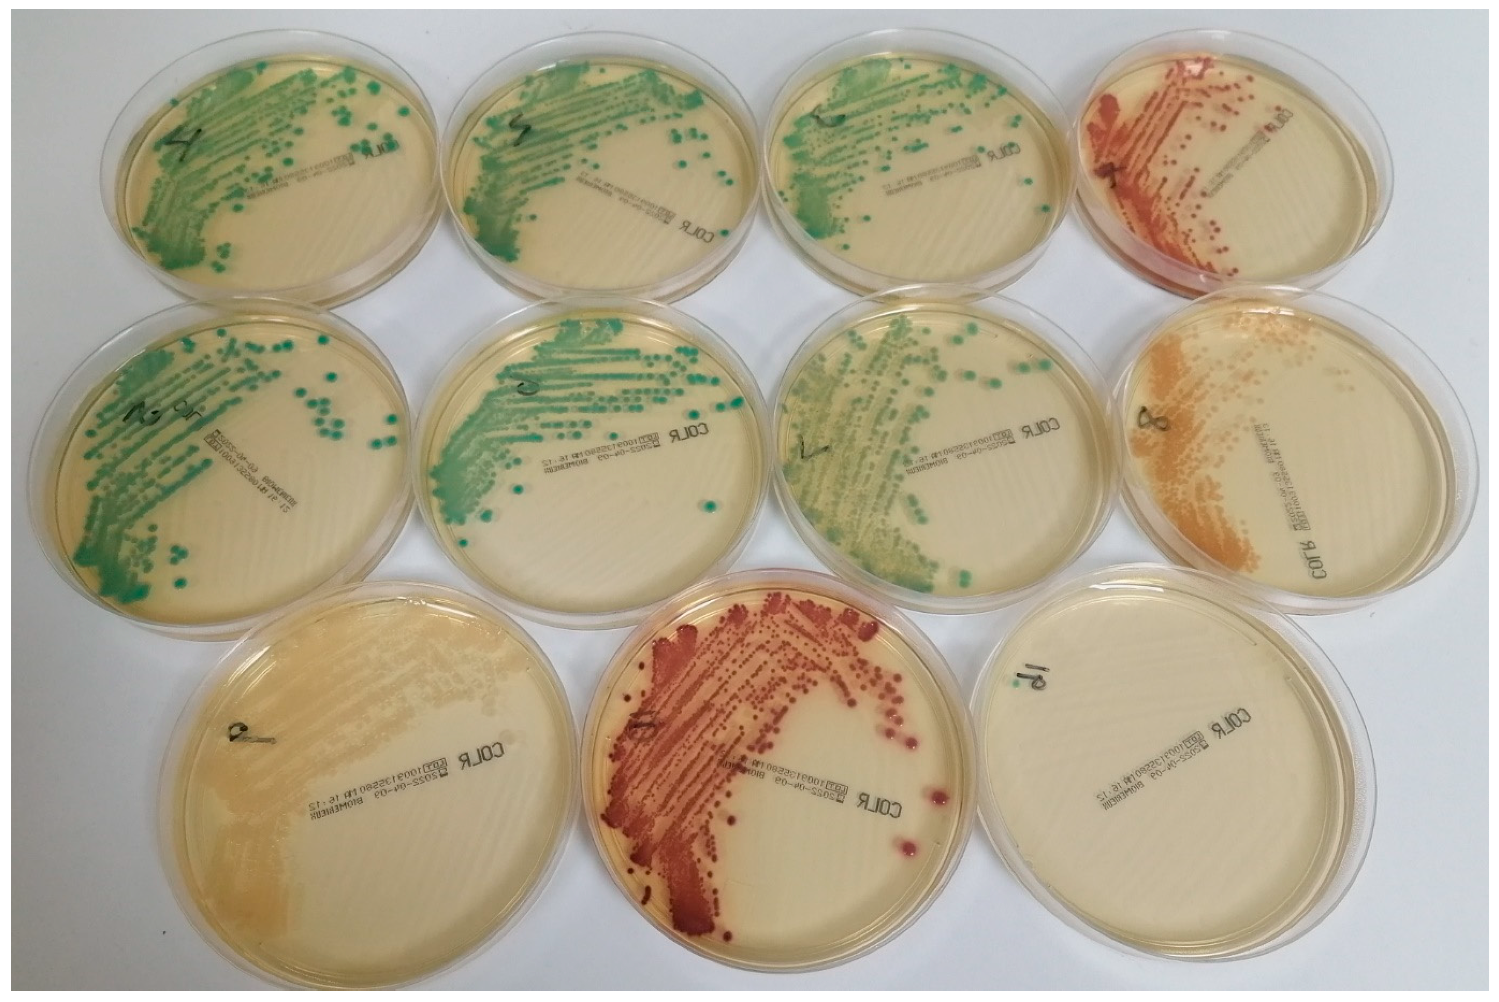
Antibiotics 13 00246 g001

The Use of CHROMID® Colistin R for the Detection of Colistin-Resistant Gram-Negative Bacteria in Positive Blood Cultures
Abstract
1. Introduction
2. Results
2.1. Recovery of Various Strains from Simulated Blood Cultures
2.2. Results with Blood Cultures from Patients in Newcastle upon Tyne, UK
2.3. Results with Blood Cultures from Patients in Hacettepe University Hospitals, Ankara, Türkiye
2.4. Ability of CHROMID® Colistin R to Detect Colistin-Resistant Gram-Negative Bacteria
2.5. Ability of CHROMID® Colistin R to Predict Colistin Resistance among Enterobacterales
2.6. False-Positive Isolates Recovered on CHROMID® Colistin R
2.7. Summary of Performance of CHROMID® Colistin R
3. Discussion
4. Methods
4.1. Preparation and Processing of Simulated Blood Cultures
4.2. Processing of Blood Cultures from Patients in Newcastle upon Tyne, UK
4.3. Processing of Blood Cultures from Patients in Hacettepe University Hospitals, Ankara, Türkiye
4.4. Interpretation of Culture Plates
4.5. Determination of the Minimum Inhibitory Concentration (MIC) of Colistin
4.6. Determination of mcr Genes Using Polymerase Chain Reaction (PCR)
4.7. Statistical Analysis
5. Conclusions
Author Contributions
Funding
Institutional Review Board Statement
Informed Consent Statement
Data Availability Statement
Acknowledgments
Conflicts of Interest
References
- Dhariwal, A.K.; Tullu, M.S. Colistin: Re-emergence of the ‘forgotten’ antimicrobial agent. J. Postgrad. Med. 2013, 59, 208–215. [Google Scholar] [CrossRef] [PubMed]
- Clancy, C.J.; Potoski, B.A.; Buehrle, D.; Nguyen, M.H. Estimating the treatment of carbapenem-resistant Enterobacteriaceae infections in the United States using antibiotic prescription data. Open Forum Infect. Dis. 2019, 6, ofz344. [Google Scholar] [CrossRef] [PubMed]
- Cavallo, I.; Oliva, A.; Pages, R.; Sivori, F.; Truglio, M.; Fabrizio, G.; Pasqua, M.; Pimpinelli, F.; Di Domenico, E.G. Acinetobac-ter baumannii in the critically ill: Complex infections get complicated. Front. Microbiol. 2023, 14, 1196774. [Google Scholar] [CrossRef] [PubMed]
- Park, J.J.; Seo, Y.B.; Lee, J.; Choi, Y.K.; Jeon, J. Colistin monotherapy versus colistin-based combination therapy for treatment of bacteremia in burn patients due to carbapenem-resistant gram negative bacteria. Burns 2020, 46, 1848–1856. [Google Scholar] [CrossRef] [PubMed]
- Paul, M.; Daikos, G.L.; Durante-Mangoni, E.; Yahav, D.; Carmeli, Y.; Benattar, Y.D.; Skiada, A.; Andini, R.; Eliakim-Raz, N.; Nutman, A.; et al. Colistin alone versus colistin plus meropenem for treatment of severe infections caused by carbapenem-resistant Gram-negative bacteria: An open-label, randomised controlled trial. Lancet Infect. Dis. 2018, 18, 391–400. [Google Scholar] [CrossRef] [PubMed]
- Satlin, M.J.; Lewis, J.S.; Weinstein, M.P.; Patel, J.; Humphries, R.M.; Kahlmeter, G.; Giske, C.G.; Turnidge, J. Clinical and Laboratory Standards Institute and European Committee on Antimicrobial Susceptibility Testing position statements on polymyxin B and colistin clinical breakpoints. Clin. Infect. Dis. 2020, 71, e523–e529. [Google Scholar] [CrossRef]
- Bhatt, P.; Tandel, K.; Shete, V.; Rathi, K.R. Burden of extensively drug-resistant and pandrug-resistant Gram-negative bacteria at a tertiary-care centre. New Microbes New Infect. 2015, 8, 166–170. [Google Scholar] [CrossRef]
- Loosli, K.; Davis, A.; Muwonge, A.; Lembo, T. Addressing antimicrobial resistance by improving access and quality of care—A review of the literature from East Africa. PLoS Negl. Trop. Dis. 2021, 15, e0009529. [Google Scholar] [CrossRef]
- Soanker, R.; Vemu, L.; Vimala, S.; Kanne, P.; Thumma, V.M.; Chavala, G. The effect of double carbapenem regimen in the management of carbapenem-resistant Klebsiella pneumoniae infections: A report of five cases. Cureus 2024, 16, e52023. [Google Scholar]
- European Committee on Antimicrobial Susceptibility Testing (EUCAST). Colistin Breakpoints—Guidance Document 2021. Available online: https://www.eucast.org/fileadmin/src/media/PDFs/EUCAST_files/Guidance_documents/Colistin_guidance_2021.pdf (accessed on 2 January 2024).
- Matuschek, E.; Åhman, J.; Webster, C.; Kahlmeter, G. Antimicrobial susceptibility testing of colistin-evaluation of seven commercial MIC products against standard broth microdilution for Escherichia coli, Klebsiella pneumoniae, Pseudomonas aeruginosa, and Acinetobacter spp. Clin. Microbiol. Infect. 2018, 24, 865–870. [Google Scholar] [CrossRef]
- Wattal, C.; Goel, N.; Oberoi, J.K.; Datta, S.; Raveendran, R. Performance of three commercial assays for colistin susceptibility in clinical isolates and mcr-1 carrying reference strain. Indian J. Med. Microbiol. 2019, 37, 488–495. [Google Scholar] [CrossRef] [PubMed]
- European Committee on Antimicrobial Susceptibility Testing (EUCAST). Breakpoint Tables for Interpretation of MICs and Zone Diameters. Version 14.0, Valid from 2024-01-01. Available online: https://www.eucast.org/fileadmin/src/media/PDFs/EUCAST_files/Breakpoint_tables/v_14.0_Breakpoint_Tables.xlsx (accessed on 2 January 2024).
- Park, J.M.; Kwon, M.; Hong, K.H.; Lee, H.; Yong, D. European Committee on Antimicrobial Susceptibility Testing-recommended rapid antimicrobial susceptibility testing of Escherichia coli, Klebsiella pneumoniae, and Staphylococcus aureus from positive blood culture bottles. Ann. Lab. Med. 2023, 43, 443–450. [Google Scholar] [CrossRef]
- Hechtman, R.K.; Kipnis, P.; Cano, J.; Seelye, S.; Liu, V.X.; Prescott, H.C. Heterogeneity of benefit from earlier time-to-antibiotics for sepsis. Am. J. Respir. Crit. Care Med. 2024. [Google Scholar] [CrossRef]
- Kumar, A.; Roberts, D.; Wood, K.E.; Light, B.; Parrillo, J.E.; Sharma, S.; Suppes, R.; Feinstein, D.; Zanotti, S.; Taiberg, L.; et al. Duration of hypotension before initiation of effective antimicrobial therapy is the critical determinant of survival in human septic shock. Crit. Care Med. 2006, 34, 1589–1596. [Google Scholar] [CrossRef] [PubMed]
- García-Fernández, S.; García-Castillo, M.; Ruiz-Garbajosa, P.; Morosini, M.I.; Bala, Y.; Zambardi, G.; Cantón, R. Performance of CHROMID® Colistin R agar, a new chromogenic medium for screening of colistin-resistant Enterobacterales. Diagn. Microbiol. Infect. Dis. 2019, 93, 1–4. [Google Scholar] [CrossRef]
- Åkerlund, A.; Jonasson, E.; Matuschek, E.; Serrander, L.; Sundqvist, M.; Kahlmeter, G.; RAST Study Group. EUCAST rapid antimicrobial susceptibility testing (RAST) in blood cultures: Validation in 55 European laboratories. J. Antimicrob. Chemother. 2020, 75, 3230–3238. [Google Scholar] [CrossRef]
- Leshaba, T.M.S.; Mbelle, N.M.; Osei Sekyere, J. Current and emerging polymyxin resistance diagnostics: A systematic review of established and novel detection methods. J. Appl. Microbiol. 2022, 132, 8–30. [Google Scholar] [CrossRef]
- Osei Sekyere, J.; Sephofane, A.K.; Mbelle, N.M. Comparative evaluation of CHROMagar COL-APSE, MicroScan Walkaway, ComASP Colistin, and Colistin MAC test in detecting colistin-resistant Gram-negative bacteria. Sci. Rep. 2020, 10, 6221. [Google Scholar] [CrossRef]
- van Hout, D.; Janssen, A.B.; Rentenaar, R.J.; Vlooswijk, J.P.M.; Boel, C.H.E.; Bonten, M.J.M. The added value of the selective SuperPolymyxin medium in detecting rectal carriage of Gram-negative bacteria with acquired colistin resistance in intensive care unit patients receiving selective digestive decontamination. Eur. J. Clin. Microbiol. Infect. Dis. 2020, 39, 265–271. [Google Scholar] [CrossRef]
- Malli, E.; Papagiannitsis, C.C.; Xitsas, S.; Tsilipounidaki, K.; Petinaki, E. Implementation of the Rapid Polymyxin™ NP test directly to positive blood cultures bottles. Diagn. Microbiol. Infect. Dis. 2019, 95, 114889. [Google Scholar] [CrossRef]
- Fonseca, E.; Silva, D.; Silva-Dias, A.; Gomes, R.; Martins-Oliveira, I.; Ramos, M.H.; Rodrigues, A.G.; Cantón, R.; Pina-Vaz, C. Evaluation of rapid colistin susceptibility directly from positive blood cultures using a flow cytometry assay. Int. J. Antimicrob. Agents 2019, 54, 820–823. [Google Scholar] [CrossRef] [PubMed]
- Bala, Y.; Fabre, P.; Senot, F.; Loubet, M.; Brossault, L.; Vrignaud, M.; Roche, J.M.; Ghirardi, S.; Zambardi, G. Can CHROMID(R) Colistin R agar (COLR) be used to test colistin susceptibility in Enterobacteriaceae? In Proceedings of the 28th European Congress of Clinical Microbiology and Infectious Diseases, Madrid, Spain, 21–24 April 2018. [Google Scholar]
- Fukuzawa, S.; Sato, T.; Aoki, K.; Yamamoto, S.; Ogasawara, N.; Nakajima, C.; Suzuki, Y.; Horiuchi, M.; Takahashi, S.; Yokota, S.I. High prevalence of colistin heteroresistance in specific species and lineages of Enterobacter cloacae complex derived from human clinical specimens. Ann. Clin. Microbiol. Antimicrob. 2023, 22, 60. [Google Scholar] [CrossRef] [PubMed]
- Lo-Ten-Foe, J.R.; de Smet, A.M.; Diederen, B.M.; Kluytmans, J.A.; van Keulen, P.H. Comparative evaluation of the VITEK 2, disk diffusion, etest, broth microdilution, and agar dilution susceptibility testing methods for colistin in clinical isolates, including heteroresistant Enterobacter cloacae and Acinetobacter baumannii strains. Antimicrob. Agents Chemother. 2007, 51, 3726–3730. [Google Scholar] [CrossRef] [PubMed]
- Clinical and Laboratory Standards Institute (CLSI). Methods for Dilution Antimicrobial Susceptibility Tests for Bacteria That Grow Aerobically, 11th ed.; CLSI standard M07; Clinical and Laboratory Standards Institute: Wayne, PA, USA, 2018; Available online: https://clsi.org/media/1928/m07ed11_sample.pdf (accessed on 2 January 2024).
- Li, J.; Shi, X.; Yin, W.; Wang, Y.; Shen, Z.; Ding, S.; Wang, S. A multiplex SYBR green real-time PCR assay for the detection of three colistin resistance genes from cultured bacteria, feces, and environment samples. Front. Microbiol. 2017, 8, 2078. [Google Scholar] [CrossRef]
| No. of Isolates (n) from: | ||
|---|---|---|
| Newcastle upon Tyne (UK) | Ankara (Türkiye) | |
| Acinetobacter baumannii complex | 1 | 7 |
| Acinetobacter lwoffii | 2 | - |
| Acinetobacter species | 4 | 1 |
| Acinetobacter ursingii | 1 | - |
| Aeromonas species | 1 | - |
| Citrobacter freundii complex | 6 | - |
| Citrobacter koseri | 5 | - |
| Enterobacter cloacae group | 12 | 5 |
| Escherichia coli | 181 | 28 |
| Klebsiella oxytoca | 12 | 1 |
| Klebsiella pneumoniae group | 56 | 14 |
| Kluyvera cryocrescens | 1 | - |
| Mixta calida | - | 1 |
| Moraxella osloensis | 1 | - |
| Morganella morganii | 3 | - |
| Neisseria species | 1 | - |
| Pantoea species | 6 | - |
| Proteus mirabilis | 19 | - |
| Pseudomonas aeruginosa | 20 | 4 |
| Pseudomonas koreensis | 1 | - |
| Pseudomonas putida group | 3 | 1 |
| Pseudomonas species | 3 | - |
| Pseudomonas stutzeri | 2 | - |
| Raoultella species | 1 | - |
| Rhizobium radiobacter | 1 | - |
| Salmonella Colindale | 1 | - |
| Salmonella Paratyphi A | 1 | - |
| Salmonella species | - | 1 |
| Salmonella Typhi | 3 | - |
| Serratia marcescens group | 12 | 1 |
| Sphingobacterium species | 1 | - |
| Stenotrophomonas maltophilia | 2 | 2 |
| Superficieibacter electus | 1 | - |
| Total | 364 | 66 |
| Simulated Blood Cultures (UK) | Detected | Real Blood Cultures (UK) | Detected | Real Blood Cultures (Türkiye) | Detected | Grand Total (All Samples) | Detected | |
|---|---|---|---|---|---|---|---|---|
| A. baumannii complex | 0 | 0 | 0 | 0 | 1 | 1 | 1 | 1 |
| Enterobacter cloacae group | 2 | 2 | 2 | 0 | 1 | 1 | 5 | 3 |
| Escherichia coli | 2 | 2 | 1 | 1 | 0 | 0 | 3 | 3 |
| Klebsiella pneumoniae group | 5 | 5 | 1 | 1 | 5 | 4 | 11 | 10 |
| Pseudomonas aeruginosa | 1 | 1 | 0 | 0 | 0 | 0 | 1 | 1 |
| Pseudomonas putida group | 0 | 0 | 1 | 0 | 0 | 0 | 1 | 0 |
| Salmonella species | 1 | 1 | 0 | 0 | 0 | 0 | 1 | 1 |
| Total (acquired resistance) | 11 | 11 | 5 | 2 | 7 | 6 | 23 | 19 |
| Morganella morganii | 0 | 0 | 3 | 3 | 0 | 0 | 3 | 3 |
| Proteus mirabilis | 0 | 0 | 19 | 19 | 0 | 0 | 19 | 19 |
| Serratia marcescens group | 0 | 0 | 11 | 11 | 1 | 1 | 12 | 12 |
| Total (intrinsic resistance) | 0 | 0 | 33 | 33 | 0 | 0 | 34 | 34 |
| Grand Total | 11 | 11 | 38 | 35 | 8 | 7 | 57 | 53 |
| Total (n) | Colistin Susceptible (n) | Growth on CHROMID® Colistin R. (n) | Colistin Resistant (n) | Growth on CHROMID® Colistin R. (n) | |
|---|---|---|---|---|---|
| Citrobacter freundii complex | 6 | 6 | 0 | 0 | 0 |
| Citrobacter koseri | 5 | 5 | 0 | 0 | 0 |
| Enterobacter cloacae group | 19 | 14 | 0 | 5 | 3 |
| Escherichia coli | 211 | 208 | 1 | 3 | 3 |
| Klebsiella oxytoca | 13 | 13 | 0 | 0 | 0 |
| Klebsiella pneumoniae group | 75 | 64 | 2 | 11 | 10 |
| Kluyvera cryocrescens | 1 | 1 | 0 | 0 | 0 |
| Mixta calida | 1 | 1 | 0 | 0 | 0 |
| Morganella morganii | 3 | 0 | 0 | 3 | 3 |
| Pantoea species | 6 | 6 | 0 | 0 | 0 |
| Proteus mirabilis | 19 | 0 | 0 | 19 | 19 |
| Raoultella species | 1 | 1 | 0 | 0 | 0 |
| Salmonella species | 7 | 6 | 0 | 1 | 1 |
| Serratia marcescens group | 13 | 1 | 0 | 12 | 12 |
| Superficieibacter electus | 1 | 1 | 0 | 0 | 0 |
| Total Enterobacterales | 381 | 327 | 3 | 54 | 51 |
| Total isolates considered | 434 | ||
| True-positives | 53 | Sensitivity (%) | 93.0 |
| False-positives | 9 | Specificity (%) | 97.6 |
| False-negatives | 4 | Positive predictive value (%) | 85.5 |
| True-negatives | 368 | Negative predictive value (%) | 98.9 |
| Total Enterobacterales | 381 | ||
| True-positives | 51 | Sensitivity (%) | 94.4 |
| False-positives | 3 | Specificity (%) | 99.1 |
| False-negatives | 3 | Positive predictive value (%) | 94.4 |
| True-negatives | 324 | Negative predictive value (%) | 99.1 |
Disclaimer/Publisher’s Note: The statements, opinions and data contained in all publications are solely those of the individual author(s) and contributor(s) and not of MDPI and/or the editor(s). MDPI and/or the editor(s) disclaim responsibility for any injury to people or property resulting from any ideas, methods, instructions or products referred to in the content. |
© 2024 by the authors. Licensee MDPI, Basel, Switzerland. This article is an open access article distributed under the terms and conditions of the Creative Commons Attribution (CC BY) license (https://creativecommons.org/licenses/by/4.0/).
Share and Cite
Marrs, E.C.L.; Milburn, O.; Eltringham, G.J.; Fenwick, D.J.C.; Orenga, S.; Hazırolan, G.; Zarakolu, P.; Perry, J.D. The Use of CHROMID® Colistin R for the Detection of Colistin-Resistant Gram-Negative Bacteria in Positive Blood Cultures. Antibiotics 2024, 13, 246. https://doi.org/10.3390/antibiotics13030246
Marrs ECL, Milburn O, Eltringham GJ, Fenwick DJC, Orenga S, Hazırolan G, Zarakolu P, Perry JD. The Use of CHROMID® Colistin R for the Detection of Colistin-Resistant Gram-Negative Bacteria in Positive Blood Cultures. Antibiotics. 2024; 13(3):246. https://doi.org/10.3390/antibiotics13030246
Chicago/Turabian StyleMarrs, Emma C. L., Olivia Milburn, Gary J. Eltringham, Danielle J. C. Fenwick, Sylvain Orenga, Gulsen Hazırolan, Pinar Zarakolu, and John D. Perry. 2024. "The Use of CHROMID® Colistin R for the Detection of Colistin-Resistant Gram-Negative Bacteria in Positive Blood Cultures" Antibiotics 13, no. 3: 246. https://doi.org/10.3390/antibiotics13030246
APA StyleMarrs, E. C. L., Milburn, O., Eltringham, G. J., Fenwick, D. J. C., Orenga, S., Hazırolan, G., Zarakolu, P., & Perry, J. D. (2024). The Use of CHROMID® Colistin R for the Detection of Colistin-Resistant Gram-Negative Bacteria in Positive Blood Cultures. Antibiotics, 13(3), 246. https://doi.org/10.3390/antibiotics13030246

